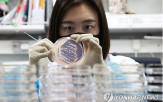
식중독,개최,강화,예방

지난 주요뉴스 한국경제TV에서 선정한 지난 주요뉴스 뉴스썸 한국경제TV 웹사이트에서 접속자들이 많이 본 뉴스 한국경제TV 기사만 onoff
-
리가켐바이오, 미국 바이오텍 노바락으로부터 신규 항체 도입 계약 체결 2026-02-24 16:32:06
‘VISION 2030’ 조기 달성을 위해 매년 3~5개의 신규 ADC 후보물질을 확보하고 임상 단계로 진입시키는 전략을 가속화하고 있으며, 이번 항체 기술도입 계약을 체결한 노바락을 포함한 국내외 우수 파트너사들과의 전략적 협력을 통해 파이프라인 경쟁력을 강화하고 있다. 김유림 기자 youforest@hankyung.com
- 뉴스 > IT·과학
- 바로가기

-
롯데월드, 화이트데이 행운의 주인공…'단 한 커플'이 롯데월드 통째로 즐긴다 2026-02-24 16:31:16
단독으로 즐길 수 있는 특별한 초대와 함께 ‘황금 로티’ 5돈이 주어지고, 2등 두 명에게는 시그니엘 숙박권이 증정된다. 당첨자는 2월 27일 금요일 오후 3시, 롯데월드 공식 유튜브 라이브 방송을 통해 공개할 예정이다. 더 자세한 안내는 롯데월드 홈페이지 및 SNS에서 확인할 수 있다. 김지은 기자 jekim@hankyung.com
- 뉴스 > 생활문화
- 바로가기

-
김여정, 노동당 장관급으로 승진…北, 대외 메시지는 '침묵' 2026-02-24 16:30:20
전문가들은 평가한다. 양무진 북한대학원대 석좌교수는 "당 대회를 대외 전략 발신보다 당의 영도력 강화, 내부 체제 공고화 계기로 삼고자 하는 의도"라면서도 "북미대화를 염두에 두고 전략적으로 메시지를 비공개했을 수 있어 최종 결정서 문안을 확인해 봐야 한다"고 분석했다. 이현일 기자 hiuneal@hankyung.com
- 뉴스 > 정치
- 바로가기

-
[AI픽] 식중독도 AI로 막는다…원인균 신속 발견 2026-02-24 16:30:01
(서울=연합뉴스) 유한주 기자 = 식품의약품안전처는 청주오스코에서 관계부처·지자체·협회 등이 참여하는 2026년도 범정부 식중독대책협의회 고위급 회의를 개최하고 식중독 예방대책을 논의했다고 24일 밝혔다. 올해 정부는 AI(인공지능) 및 과학 기반 식중독 안전관리 체계 구축, 생선부터 소비까지 빈틈없는 식중독...
- 뉴스 > 경제
- 바로가기
-
숲속 금빛 햇살을 손목에…다카이치가 李대통령에게 선물한 그 시계 2026-02-24 16:29:55
지난 1월 13~14일 진행된 한·일 정상회담에서 이재명 대통령의 취미가 등산인 점을 고려해 선물한 시계로 주목받았다. 아웃도어 모험가들에게 믿음직한 동반자가 돼줄 이 30주년 기념 모델은 브랜드 플래그십 스토어인 카시오 스토어 도산 및 전국 백화점 매장에서 만나볼 수 있다. 김규한 기자 twins@hankyung.com
- 뉴스 > 경제
- 바로가기

-
엠디루사, 네 개의 다이아몬드로 찬란한 빛 완성한 '러스터 컬렉션' 론칭 2026-02-24 16:27:50
지향하는 프리미엄 가치를 충실히 담아냈다. 러스터 컬렉션을 비롯한 엠디루사의 모든 컬렉션은 롯데백화점 잠실점과 신세계백화점 센텀시티점에서 판매하고 있다. 561 공식 브랜드관에서 온라인 구매도 가능하다. 이 외에 롯데백화점 노원점과 롯데백화점 인천점 오픈을 앞두고 있다. 김지은 기자 jekim@hankyung.com
- 뉴스 > 생활문화
- 바로가기

-
LH·성남시, 상대원3구역 재개발 사업시행협약 체결 2026-02-24 16:27:10
상대원3구역 재개발 사업시행협약 체결 (서울=연합뉴스) 홍국기 기자 = 한국토지주택공사(LH)는 24일 성남시와 상대원3구역 재개발 사업시행협약을 체결했다고 밝혔다. 상대원3구역은 LH가 성남 구도심에서 추진하는 '2030-1·2단계 순환정비방식 재개발 사업'의 마지막 구역이다. 구역 면적 45만㎡에 약 8천700...
- 뉴스 > 경제
- 바로가기

-
[그래픽] SK하이닉스 주가 추이 2026-02-24 16:27:03
[그래픽] SK하이닉스 주가 추이 (서울=연합뉴스) 원형민 기자 = 24일 한국거래소에 따르면 SK하이닉스[000660]는 전장 대비 5.68% 오른 100만5천원에 거래를 마쳤다. circlemin@yna.co.kr (끝) <저작권자(c) 연합뉴스, 무단 전재-재배포, AI 학습 및 활용 금지>
- 뉴스 > 경제
- 바로가기
-
"이란서 군용 헬기 추락…최소 2명 사망" 2026-02-24 16:26:46
(서울=연합뉴스) 오수진 기자 = 이란에서 군용 헬리콥터가 24일(현지시간) 추락해 최소 2명이 사망했다고 AFP 통신이 보도했다. 이란 국영 TV에 따르면 이날 이란 중부 이스파한에서 이란 공군 소속 헬기 한 대가 추락해 조종사와 부조종사가 모두 숨졌다. 이란 국영 TV는 아직 추락 원인이 무엇인지는 보도하지 않았다....
- 뉴스 > 정치
- 바로가기

-
바이젠셀 "NK/T세포림프종 임상2상, 환자 95% 재발 없이 2년간 생존" 2026-02-24 16:24:13
NK/T세포림프종 치료제가 될 것”이라며, “치료 옵션이 절실한 환우들에게 신속히 공급될 수 있도록 허가 신청 및 상업화 절차를 차질 없이 수행하겠다”고 밝혔다. 또한 “긍정적인 임상 데이터를 기반으로 국내외 시장에서 강력한 상업화 모멘텀을 만들어 나갈 것”이라고 강조했다. 이민형 기자 meaning@hankyung.com
- 뉴스 > IT·과학
- 바로가기







